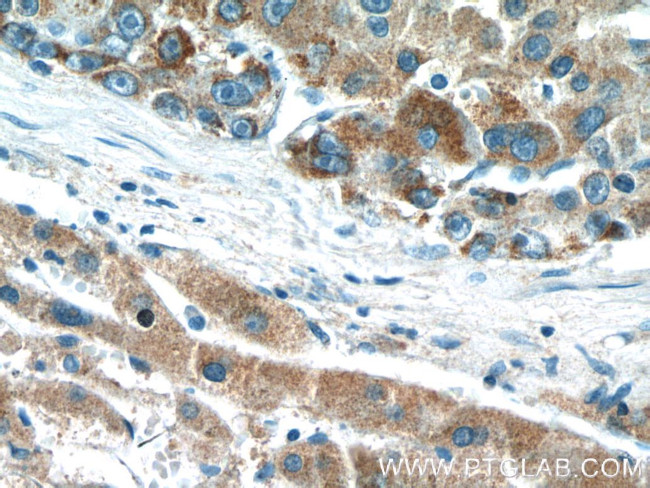
DMGDH Antibody in Immunohistochemistry (Paraffin) (IHC (P))

Search
Proteintech
DMGDH Polyclonal Antibody
{{$productOrderCtrl.translations['antibody.pdp.commerceCard.promotion.promotions']}}
{{$productOrderCtrl.translations['antibody.pdp.commerceCard.promotion.viewpromo']}}
{{$productOrderCtrl.translations['antibody.pdp.commerceCard.promotion.promocode']}}: {{promo.promoCode}} {{promo.promoTitle}} {{promo.promoDescription}}. {{$productOrderCtrl.translations['antibody.pdp.commerceCard.promotion.learnmore']}}
产品信息
24813-1-AP
种属反应
已发表种属
宿主/亚型
分类
类型
抗原
偶联物
形式
浓度
规格
纯化类型
保存液
内含物
保存条件
运输条件
产品详细信息
Immunogen sequence: ARESYGFNN IVGYPKEERF AGRPTQRVSG LYQRLESKCS MGFHAGWEQP HWFYKPGQDT QYRPSFRRTN WFEPVGSEYK QVMQRVAVTD LSPFGKFNIK GQDSIRLLDH LFANVIPKVG FTNISHMLTP KGRVYAELTV SHQSPGEFLL ITGSGSELHD LRWIEEEAVK GGYDVEIKNI TDELGVLGVA GPQARKVLQK LTSEDLSDDV FKFLQTKSLK VSNIPVTAIR ISYTGELGWE LYHRREDSVA LYDAIMNAGQ EEGIDNFGTY AMNALRLEKA FRAWGLEMNC DTNPLEAGLE YFVKLNKDQN SCFAHFKEEN GWVSRWAIRP Y (284-613 aa encoded by BC022388)
靶标信息
This gene encodes an enzyme involved in the catabolism of choline, catalyzing the oxidative demethylation of dimethylglycine to form sarcosine. The enzyme is found as a monomer in the mitochondrial matrix, and uses flavin adenine dinucleotide and folate as cofactors. Mutation in this gene causes dimethylglycine dehydrogenase deficiency, characterized by a fishlike body odor, chronic muscle fatigue, and elevated levels of the muscle form of creatine kinase in serum. Alternative splicing results in multiple transcript variants.
仅用于科研。不用于诊断过程。未经明确授权不得转售。
生物信息学
蛋白别名: Dimethylglycine dehydrogenase, mitochondrial; EC 1.5.99.2; M2GD; ME2GLYDH; unnamed protein product
基因别名: 1200014D15Rik; AI787269; DMGDH; DMGDHD; ME2GLYDH
UniProt ID: (Human) Q9UI17, (Mouse) Q9DBT9
Entrez Gene ID: (Human) 29958, (Mouse) 74129, (Rat) 245961